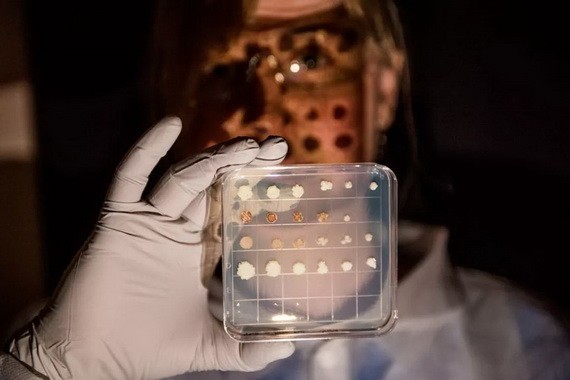
蓍果脂解酵母的不同培養基。

很大程度是出於經濟因素考慮。大到以政府為主導的能源網路,小到生活中一些紡織品的生產和其他產品的製造。其所涉及的商品很多原料都取之於化石燃料,如果停止使用或全部替代它們,將會付出較大的經濟代價。
於是科學家設想,假如人們可以找到一種低成本且高效的化石燃料替代品,或許有可能改善因燃料燃燒帶來的環境污染。
近日,美國太平洋西北國家實驗室的生物學家提出,用一種高價值的化學物質製備酵衣康酸,或可作為化石燃料衍生產品的替代物。
數據科學家尼拉傑‧庫馬爾教授及其團隊成員使用數據集成和超級計算來影響微生物的工程變化,進而影響微生物的新陳代謝。基於之前大量的實驗模擬,該團隊有望利用從過往樣本中得出的經驗批量地生產衣康酸。
科學家製備出化石燃料替代物
自然界能找到生產衣康體的微生物並不容易,一方面品種很少有自然微生物在化工、能源、藥物領域能滿足不同的化學品需求;另一方面,自然微生物的經濟利用價值也比較低。
因此,傳統的生物製造面臨很多瓶頸,能否找到可持續性的綠色方式製備替代燃料,提高環境和經濟價值至關重要。
先不論化石燃料能否用完,或是人類因為環境問題停止使用化石燃料。單純假設化石燃料變得過於昂貴,在此條件下,世界經濟和人口增長把對能源供應要求提高到科技無法滿足的限度。
庫馬爾從合成生物學中獲得了新的靈感,嘗試利用微生物作為廉價的生產材料製備衣康酸。
庫馬爾說:“我們需要確定衣康酸產生途徑中的哪些基因可以改變,哪些無法改變,我們可以輕鬆地估算這些酵母可以產生多少化學物質。這項工作的最大挑戰在於,是否能找到細胞健康和生物生產之間的平衡。”
隨著合成生物學技術不斷獲得進展和突破,細胞工廠的構建能力有了很大提高,這讓快速製備各種化學品成為可能。科學家可以通過最優合成途徑的設計、合成途徑的創建、合成途徑的優化和細胞製備性能的提升 4 個方式來實現。
依託合成生物技術,科學家可以製備更多的高效細胞工廠,於是烯烴、生產長鏈醇等典型化學品燃料陸續問世。而衣康酸在可再生化學構建模組所具備的潛力,與化石燃料有關的產品可以被替代。2004 年,衣康酸被美國能源部評價為“生物質中附加值最高的化學品”之一。
RNA測序數據的計算預測與實驗結果吻合
衣康酸是由幾種真菌天然產生的,美國太平洋西北國家實驗室科學家戴子宇(音譯)借用了從其他真菌生物的基因,使脂溶耶氏菌能夠產生衣康酸這種化學物質。
生物學家愛琳‧布雷德維格對不同基因組合的改良酵母研究頗深。後來,庫馬爾找到她進行合作,希望構建出更加有效的衣康體。當時,布雷德維格和的她團隊已經製備出了一份改良酵母的代謝和蛋白質組學剖面,然後把這些數據毫無保留地傳遞給庫馬爾。
根據“設計-建造-測試-學習”的策略,庫馬爾和他的研究助理安德魯‧麥克諾頓利用機器學習來檢查這一特徵,觀察哪些非必需基因可以從酵母中移除,哪些有用的基因可以進一步添加,進而達到增加衣康酸的產量的目的。
一旦他們選擇用基因來“設計”生物體,就可以立刻開始製備衣康體。根據庫馬爾和麥克諾頓的預測,他們在布雷德維格創造的不同版本酵母中添加或刪除了某些基因之後,發現RNA 測序數據的計算預測與實驗結果吻合。
布雷德維格表示:“目前,這項研究還處於早期階段,但是在未來它可以表現出很大的潛力。通過機器學習和科學家的推理可以解釋,用新的思路來思考酵母等複雜細胞系統如何對單個基因變化做出反應,超出了僅通過新陳代謝建模的可能性。”
酵母和其他微生物雖然可以容易地生產像乙醇一樣的高產量化學品,但是也面臨著一些挑戰,庫馬爾希望將機器學習與代謝建模和多組學數據集相結合的系統運用於實際生產中,攻克這一難題◆

























